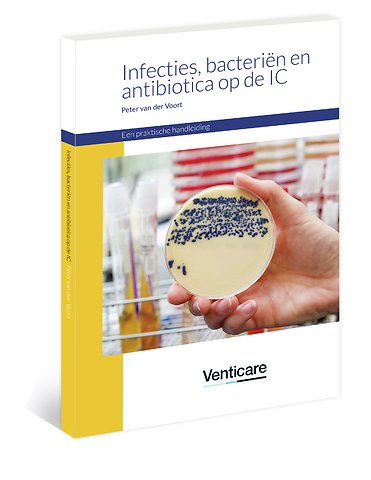

Prof.dr. P.H.J. (Peter) van der Voort, hoogleraar Intensive Care Geneeskunde, Rijksuniversiteit Groningen en UMCG; hoogleraar Health Care, TIAS School for Business and Society, Tilburg University.
Meer over Peter van der VoortInfecties, bacteriën en antibiotica op de IC
Paperback Nederlands 2018 1e druk 9789072651372Samenvatting
Infecties zijn op de intensive care veelvoorkomend. Patiënten worden met een infectie opgenomen, of kunnen een infectie oplopen op de intensive care. Ernstige sepsis en septische shock zijn belangrijke doodsoorzaken bij intensive care patiënten.
Antibiotica zijn effectieve medicijnen indien tijdig toegediend en ook passend bij de bacterie die de infectie veroorzaakt. Infecties – bacteriën – antibiotica zijn dus een drie-eenheid, die voor een effectieve behandeling gedegen kennis behoeft. Deze praktische handleiding geeft op beknopte wijze voor artsen en verpleegkundigen de basiskennis om op de intensive care het antibiotisch beleid te begrijpen en te maken.
Specificaties
Lezersrecensies
Rubrieken
- advisering
- algemeen management
- coaching en trainen
- communicatie en media
- economie
- financieel management
- inkoop en logistiek
- internet en social media
- it-management / ict
- juridisch
- leiderschap
- marketing
- mens en maatschappij
- non-profit
- ondernemen
- organisatiekunde
- personal finance
- personeelsmanagement
- persoonlijke effectiviteit
- projectmanagement
- psychologie
- reclame en verkoop
- strategisch management
- verandermanagement
- werk en loopbaan